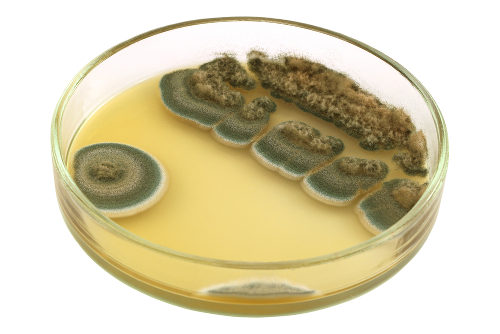
erros comuns ao tomar penicilina

Descubra o que é penicilina: o acidente científico que salvou milhões de vidas e revolucionou a medicina moderna.
Como a penicilina funciona no seu corpo para combater infecções bacterianas
O grande segredo? Ela ataca a estrutura que mantém as bactérias vivas.
Vamos combinar: você já se perguntou como um simples remédio derruba uma infecção séria?
A verdade é a seguinte: a penicilina inibe a síntese da parede celular bacteriana, segundo os manuais de farmacologia.
Mas preste atenção: isso só funciona contra bactérias Gram-positivas, como as que causam amigdalite.
Pode confessar: parece mágica, mas é pura ciência aplicada.
Olha só: sem essa parede, a bactéria literalmente explode e morre, limpando sua infecção em dias.
Aqui está o detalhe: por isso ela foi crucial na Segunda Guerra Mundial, salvando soldados de gangrena.
No Brasil, ainda é um dos antibióticos mais prescritos, com custo médio de R$ 15 a R$ 50 por caixa.
E o pulo do gato? Seu médico escolhe entre tipos como penicilina G (injetável) ou amoxicilina (oral) baseado na gravidade.
Em Destaque 2026: Penicilina é um antibiótico derivado de fungos do gênero Penicillium, utilizado no tratamento de infecções bacterianas.
O Que É Penicilina e Para Que Serve: Um Marco na Medicina
Vamos combinar: falar de penicilina é falar de um antes e um depois na história da medicina. Sabe aquela sensação de alívio quando um problema sério tem solução? A penicilina trouxe isso para milhões de pessoas.
Ela é, na prática, o primeiro antibiótico que realmente funcionou em larga escala. Antes dela, uma infecção bacteriana simples podia ser uma sentença de morte. A penicilina mudou esse jogo completamente.
Seu principal papel é combater infecções causadas por bactérias. Ela age de forma específica, atacando a estrutura que protege essas bactérias, o que leva à sua destruição.
| Descoberta: 1928 por Alexander Fleming |
| Tipo: Primeiro antibiótico de uso amplo |
| Mecanismo: Inibe a síntese da parede celular bacteriana |
| Eficácia Principal: Bactérias Gram-positivas |
| Origem: Derivada de fungos |
| Uso: Prescrição médica obrigatória |
| Desafio: Resistência bacteriana crescente |
O Que É Penicilina: Definição e Importância

A penicilina é, fundamentalmente, um grupo de antibióticos que têm origem natural, produzidos por certos tipos de fungos. Sua descoberta, que vamos detalhar já já, foi um verdadeiro divisor de águas.
Antes de sua popularização, doenças como pneumonia, sífilis e infecções de garganta eram assustadoras. A penicilina ofereceu uma esperança real e um tratamento eficaz, salvando incontáveis vidas e mudando o curso da medicina moderna.
História da Penicilina: A Descoberta de Alexander Fleming
A história da penicilina é daquelas que mostram como a ciência pode ser surpreendente. Tudo aconteceu em 1928, no laboratório de Alexander Fleming, um cientista escocês.
Fleming, distraído com uma viagem, deixou placas de cultura de bactérias Staphylococcus em sua bancada. Ao retornar, notou algo peculiar: em uma das placas, um mofo (um fungo) havia crescido, e ao redor dele, as bactérias não se desenvolviam. Era uma zona de inibição clara.
Esse mofo era do gênero *Penicillium*. Fleming, com sua perspicácia, percebeu o potencial do que estava vendo. Ele isolou a substância ativa e a chamou de penicilina. A verdade é que ele deu o primeiro passo, mas a produção em massa e o uso clínico vieram depois, com outros cientistas.
Como a Penicilina Age Contra Infecções Bacterianas
A forma como a penicilina atua é um exemplo clássico de como um medicamento pode ser específico. Ela não mata todas as células, mas foca em um ponto vital das bactérias.
O grande segredo? A penicilina interfere diretamente na construção da parede celular das bactérias. Pense nessa parede como o ‘esqueleto’ que dá forma e proteção à bactéria. Sem ela, a bactéria fica vulnerável.
Ao impedir a formação dessa parede, a penicilina deixa a bactéria exposta às pressões internas e externas, levando à sua lise, ou seja, à sua destruição. É um ataque preciso e eficaz contra o inimigo.
Tipos de Penicilina e Seus Usos no Tratamento
Nem toda penicilina é igual. Ao longo do tempo, a ciência desenvolveu variações para aumentar sua eficácia e espectro de ação. Vamos ver os exemplos mais comuns:
- Penicilina G: Considerada a penicilina ‘original’, é eficaz contra muitas bactérias Gram-positivas e algumas Gram-negativas. É frequentemente usada para tratar infecções como sífilis e faringite estreptocócica.
- Amoxicilina: Uma das mais conhecidas e prescritas. É uma penicilina semissintética, com maior absorção oral e um espectro de ação mais amplo, cobrindo mais tipos de bactérias. É comum para infecções de ouvido, garganta e trato urinário.
- Ampicilina: Similar à amoxicilina, também com boa absorção e espectro ampliado.
Cada tipo tem indicações específicas, e a escolha depende do tipo de infecção e da bactéria causadora. Por isso, a prescrição médica é fundamental.
Efeitos Colaterais da Penicilina: Alergias e Reações

Apesar de ser um medicamento salvador, a penicilina não é isenta de riscos. O efeito colateral mais conhecido e potencialmente grave é a alergia à penicilina.
As reações alérgicas podem variar de leves, como erupções cutâneas e coceira, a graves, como anafilaxia – uma emergência médica que pode levar à dificuldade respiratória e queda da pressão arterial.
É crucial que qualquer pessoa com histórico de alergia a antibióticos informe o médico. Para entender melhor sobre alergias, consulte fontes confiáveis como o NHS e o CDC.
Resistência Bacteriana à Penicilina: Causas e Prevenção
Aqui está um dos maiores desafios da medicina moderna: a resistência bacteriana. As bactérias são ‘espertas’ e, com o tempo e o uso inadequado de antibióticos, aprendem a se defender.
O uso excessivo ou incorreto da penicilina (e de outros antibióticos) seleciona as bactérias mais resistentes. Elas sobrevivem, se multiplicam e passam essa resistência adiante, tornando o medicamento menos eficaz.
A prevenção passa por usar antibióticos apenas quando prescritos por um médico, completar todo o ciclo do tratamento e evitar a automedicação. É uma responsabilidade de todos nós.
Penicilina Como Antibiótico: Mecanismo de Ação
Para aprofundar um pouco mais, vamos revisitar o mecanismo de ação. A penicilina pertence a uma classe de antibióticos chamada beta-lactâmicos.
Eles agem inibindo as enzimas transpeptidases, que são essenciais para a formação das ligações cruzadas na camada de peptidoglicano da parede celular bacteriana. Essa parede é vital para manter a integridade da bactéria.
Sem essa estrutura forte, a bactéria não consegue resistir à pressão osmótica e acaba ‘estourando’. É um efeito bactericida, ou seja, mata a bactéria diretamente.
Penicilina Derivada de Fungo: Origem Natural
É fascinante pensar que um dos maiores avanços médicos veio de um simples mofo, não é mesmo? A penicilina, em sua forma original, é um metabólito secundário produzido por fungos do gênero *Penicillium*.
Esses fungos produzem a penicilina como um mecanismo de defesa, para eliminar bactérias concorrentes em seu ambiente. Fleming, com sua observação aguçada, soube aproveitar essa ‘arma’ natural.
Hoje, a produção em larga escala envolve processos de fermentação controlada, onde cepas específicas de *Penicillium* são cultivadas em condições ideais para maximizar a produção do antibiótico.
O Legado da Penicilina: Um Avanço Que Continua a Salvar Vidas
A penicilina não foi apenas um medicamento; foi um símbolo de esperança e um motor para a revolução dos antibióticos. Sua descoberta e desenvolvimento mudaram para sempre a forma como tratamos infecções bacterianas.
Da Segunda Guerra Mundial, onde salvou inúmeros soldados, até o uso diário em clínicas e hospitais, a penicilina provou seu valor inestimável. Mesmo com os desafios da resistência bacteriana, ela continua sendo uma ferramenta essencial.
A lição que fica é clara: a ciência, aliada à observação e à persistência, pode trazer soluções incríveis. A penicilina é a prova viva disso, um presente da natureza e da genialidade humana para a saúde global.
Dicas Extras: Como Usar Esse Medicamento Com Segurança Máxima
A verdade é a seguinte: informação é o melhor remédio.
Vamos combinar que ninguém quer passar perrengue.
Anota essas dicas de ouro para não errar.
- Checklist pré-consulta: Antes de ir ao médico, anote todos os seus sintomas e há quanto tempo começaram. Liste também outros remédios que você toma. Isso agiliza o diagnóstico correto.
- Teste de alergia é obrigatório? No Brasil, o teste cutâneo (na pele) não é rotina para toda prescrição. Mas se você já teve reação a qualquer antibiótico, AVISE o médico. É a sua maior proteção.
- O pulo do gato na farmácia: Sempre confira se o genérico que você vai comprar tem o selo da ANVISA no rótulo. A qualidade é igual à do de marca, mas o preço pode ser até 70% menor.
- Erro fatal que todo mundo comete: Parar o tratamento quando os sintomas melhoram. A infecção pode não ter sido totalmente eliminada. Siga o tempo exato que o médico passou, mesmo se estiver se sentindo bem.
- Guarda inteligente: Nunca deixe os comprimidos no banheiro. O calor e a umidade estragam o princípio ativo. Guarde na embalagem original, em lugar fresco e seco.
Perguntas Frequentes (FAQ)
Penicilina para dor de garganta funciona?
Funciona apenas se a causa for bacteriana. A maioria das dores de garganta é viral, e aí esse remédio não faz efeito nenhum. Só um médico pode diferenciar através do exame clínico e, se necessário, de um teste rápido. Usar sem necessidade é jogar dinheiro fora e contribuir para a resistência bacteriana.
Qual a diferença entre penicilina e amoxicilina?
A amoxicilina é um ‘primo’ mais moderno e versátil da penicilina original. Ela é mais estável no estômago, então pode ser tomada com comida. Também age contra um leque um pouco maior de bactérias. Na prática, a amoxicilina é uma das prescrições mais comuns para infecções comuns de ouvido, sinusite e algumas pneumonias.
Posso tomar penicilina se sou alérgico?
Não. Jamais. Se você tem histórico de alergia a qualquer tipo de penicilina, o uso pode desencadear desde uma simples urticária até um choque anafilático, que é grave. Converse com seu médico sobre alternativas seguras, como a azitromicina ou a claritromicina, que são classes diferentes de antibióticos.
Conclusão: O Peso Dessa Descoberta No Seu Dia a Dia
Olha só o caminho que a gente percorreu.
De um mofo esquecido em uma placa de Petri ao medicamento que salva milhões.
A lição que fica é de humildade e ciência.
Mas preste atenção: esse poder precisa ser usado com inteligência.
Respeitar a prescrição, completar o tratamento e nunca se automedicar não são apenas conselhos. São atos de responsabilidade coletiva.
O seu primeiro passo hoje? Olhar com outros olhos a próxima receita que você receber. Entender o ‘porquê’ do remédio é tão importante quanto tomá-lo.
Compartilhe essa dica com quem você ama. A informação de qualidade salva vidas.
E aí, conta pra gente nos comentários: você já teve que usar esse tipo de tratamento? Como foi a sua experiência?

